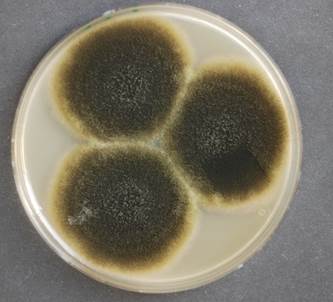

![]() Schwärze-Schimmelpilz Alternaria
Schwärze-Schimmelpilz Alternaria ![]() TÖDLICH GIFTIG! Schimmelpilzgift, Mykotoxine
TÖDLICH GIFTIG! Schimmelpilzgift, Mykotoxine
ALTERNARIA ALTERNATA (SYN. ALTERNARIA TENUIS),
ALTERNARIA TENUISSIMA, ALTERNARIA CITRI,
ALTERNARIA SOLANI, ALTERNARIA
BRASSICAE, ALTERNARIA CHLAMYDOSPORA, ALTERNARIA
DIANTHICOLA, ALTERNARIA INFECTORIA. ALS TELEOMORPHE FORMEN WERDEN PLEOSPORA
UND LEWIA GENANNT.
|
|
|
|
|
|
|
Bilder oben 1-4 und unten 1-7 von links: Dr. Herbert Seiler
(85402 Kranzberg) ©
|
|
|
|
Eigenschaften,
Erkennungsmerkmale, Besonderheiten, (Gattungen): |
||
|
Geruch: |
Unbedeutend. |
|
|
Geschmack: |
Unbedeutend. |
|
|
Fruchtkörper: |
2-20 (30) cm Ø meist braun, braungrün bis schwarz,
goldgelb, weiß- oder braun überzogener Schimmel an Pilzen, Pflanzen oder
menschlichem oder tierischen Gewebe. Bei vielen Schimmelpilzarten werden die
Fruchtkörper später immer dunkler, faulig, weich, schwärzlich, schimmelig.
Die älteren Kolonien sind größtenteils braun, braungrün bis schwarz. UV-Licht
fördert die Pigmentierung. Die überwiegend eier- bis keulenförmigen Konidien
sind auffällig quer und längs septiert und werden im reifen Zustand braun bis
schwarzbraun. Sie können in Ketten vorkommen. Es ist keine besondere
Temperaturresistenz bekannt, allerdings werden von diesen Pilzen Chlamydosporen
und fast nie thermoresistente Ascosporen produziert. Das Wachstumsoptimum
liegt bei 25-28 °C, das Maximum bei 32 °C, das Minimum bei 0 °C. |
|
|
Sporenpulver: |
Transparent, weißlich, gelblich, golden … (spec …). |
|
|
Vorkommen: |
Auf toten Fruchtkörpern von Pilzen oder anderem organischem Material.
Diese saprophytische Gattung ist weltweit stark verbreitet. Häufige
natürliche Standorte sind Boden, Pflanzen, Lebensmittel, Nüsse, Getreide,
Textilien oder feuchtes Holz. Reines Mauerwerk und Kalkputz können generell
nicht von Schimmel bewachsen werden, wohl aber Tapeten, Kleister, Leim- und
Binderfarben, Kondensate aus Küchendämpfen, Haarsprays, Parfüms, Badezusätzen
sowie auf Spinnweben und Staub. Die Arten wachsen auf Butter, da sie
lipolytisch sind. Manche sind Pflanzenpathogen; sie verursachen bei Kernobst
die Kernhausfäule, bei Beeren- und Steinobst die Braun- und Grünfäule, bei
Gemüse und Hülsenfrüchten die Schwarzfäule, bei Kohl die Krautfäule
(ALTERNARIA BRASSICAE), bei Citrusfrüchten die Nassfäule und bei Kartoffeln
Sprühfäule und Dörrfleckenkrankheit (ALTERNARIA SOLANI). Als „Feldpilze“
werden sie bei Getreide zur „Inneren Flora“, d. h. zur Mikroflora im
Raum zwischen Epidermis und Querzellen, als ebenfalls zur „Äußeren Flora“
gezählt |
|
|
Gattung: |
Schimmelpilze (Alternaria) = Schwärzepilze. ALTERNARIA
ALTERNATA und andere Arten dieser aeroben Gattung werden zu den
Schwärzepilzen gestellt. Häufig sind ALTERNARIA ALTERNATA (TENUIS),
ALTERNARIA TENUISSIMA, ALTERNARIA CITRI, ALTERNARIA SOLANI und ALTERNARIA
BRASSICAE; seltener sind ALTERNARIA CHLAMYDOSPORA, ALTERNARIA DIANTHICOLA und
ALTERNARIA INFECTORIA. Als teleomorphe Formen werden PLEOSPORA und LEWIA
genannt. |
|
|
Verwechslungsgefahr: |
Schimmel, Hefeähnlicher
Schimmelpilz, Köpfchenschimmel, Grüner Schimmelpilz, Weißstängeligkeit, Kaktuspilz, Kiefern-Braunporling, Rotspitzigkeit, Rosa Schimmelpilz, Kristallreicher
Stachelsporling, Haareis
und Kellertuch,
Helmlingschimmel,
Steinreizker,
Ozonium (sichtbares
Pilzmyzelgeflecht, hier des Haustintlings). |
|
|
Vergleich: |
Die Gattung ULOCLADIUM mit der Art ULOCLADIUM CHARTARUM lässt
sich nur schwer unterscheiden. Alternaria hat im Unterschied zu ULOCLADIUM
Konidien mit runder Basis und länglicher Spitze. |
|
|
Kommentar: |
Sollte ein Speisepilz nur teilweise verschimmelt sein, weg damit! Die
verschimmelten Bereiche durchziehen oft den ganzen Pilz, wenn dies nicht
sichtbar ist. Durch die Umwandlung Pilzeiweiß/Schimmelpilz entstehen bei
manchen Schimmelpilzarten gen-giftige Substanzen die krebserregend sein
können. Ist der Schimmel optisch bislang nicht sichtbar, stellt dies kein
Problem dar! Der Zersetzungsprozess hat noch kein gefährliches Ausmaß
erreicht. |
|
|
Hinweis: |
Schimmelpilzarten sind in der
Gefährlichkeit nicht zu unterschätzen. Einige Schimmelpilzarten werden über
die Lunge eingeatmet. Von dort aus gelangen sie über das Blut zu anderen
Organen und können dieses über die Gefäßwände angreifen. Bei stark
abwehrgeschwächten Personen kann dies zum Tode führen. Alternaria spp. sind
wie viele Schimmelpilze hygienisch nicht unbedenklich, da Mykotoxine
produziert werden (Alternariole, Altertoxine, Altenuen,
Alternariolmonomethylester, Tenuazonsäure). Es gibt klinische Isolate - meist
von Hautwunden oder nach Augenoperationen sowie bei immunsupprimierten Krebs-
und Aids-Patienten. Es werden potente Allergene produziert. |
|
|
Gifthinweise: |
||
|
Wiki-Link: |
||
|
Priorität: |
3 |
|
|
|
|
|
|
|
|
Bilder oben 1-4 von
links: Dr. Herbert Seiler (85402 Kranzberg) ©
Weitere Bestimmungshilfen und Informationen
hier:
|
|
|
|
|
|
|
Letzte Aktualisierung dieser Seite: Donnerstag, 6. Februar 2025 - 08:40:29 Uhr